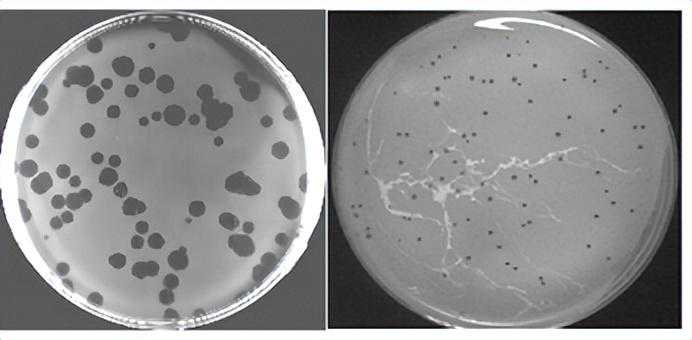

来看图片:鱼钩上的东西,是什么“肠道蜘蛛”吗?

当然不是(如果是的话蜘蛛恐惧症患者可能迅速下滑并且留言责怪)——这实际上是肠道内的噬菌体。
如图所示,那些五颜六色的“别致小东西”是生活在人体肠道中的微生物,其中,细菌占据了绝大部分。肠道菌群广泛参与和影响人的消化、代谢、免疫,加上庞大数量和与人终身相伴的地位,可以说是人体的“外挂器官”。
“哪里有猎物,哪里就有猎人。”肠道里有大量细菌,自然也有细菌的天敌就——噬菌体。噬菌体,顾名思义,就是吃细菌的东西。噬菌体是一种专门“感染”并杀死细菌的病毒(注意它是一种病毒!),它遇到细菌就会钻进其体内大量繁殖,最后从内部把细菌“裂开”,释放出成百上千新的噬菌体。新释放出来的噬菌体再去感染细菌,产生下一代噬菌体,如此循环往复。在肠道中,细菌不断繁殖,噬菌体不断猎杀,二者数量保持动态平衡。
相信聪明的读者很快能想到:我们能利用噬菌体来调节肠道菌群吗?显然,要实现这一愿景的关键在于:如何把肠道中的噬菌体分离出来。
想分离肠道中的噬菌体?没那么简单遗憾的是,分离肠道中的噬菌体,并不是一件简单的事情。
这是因为,噬菌体的生存需要钻进活细菌体内,想要在体外把噬菌体分离出来,首先需要在体外养活肠道细菌。但肠道细菌的培养,通常需要特殊的无氧环境来进行培养和操作,这使得分离的工作困难重重。
不过,事情正在起变化——4月12日,一篇题为《Large-scalephagecultivationforcommensalhumangutbacteria》的论文发表在CellHostMicrobe上,科学家首次对人体肠道共生细菌的噬菌体进行了大规模的分离培养,建立了包含200多个噬菌体的人体肠道噬菌体资源库GPIC(GutPhageIsolatesCollection)。科学家不仅实现了对人体肠道内噬菌体的分离培养,还成功实现了“大规模”,为下一步应用奠定基础。
分离噬菌体:规模很大且略显无聊为了分离到能感染人体肠道细菌的噬菌体,科学家从深圳的南山污水处理厂、福田污水处理厂收集了下水道污水样本,以及20名人类粪便混合物样本。
科学家首先把样本过滤,去除细菌等,留下小小的噬菌体。通过直接浓缩和与单菌混合培养,让各种噬菌体大量富集,得到大量噬菌体的“混合液”。
接下来,要“钓”出能够“猎杀”特定细菌的单一噬菌体:科学家预先准备了很多培养皿和411种肠道细菌,每一个培养皿平板上都只培养一种细菌,然后取出非常少量的“混合液”滴加到平板上涂抹均匀,如果“混合液”中恰好有某种噬菌体能在这种细菌上生长,就会观察到一小圈一小圈被杀死的细菌(也就是抑菌圈)。

GPIC噬菌体分离纯化流程示意图(图片来自论文)
由于一个平板上只有一种细菌,噬菌体需要依赖细菌繁殖,所以只有能杀死这个平板上细菌的噬菌体才能大量繁殖和存活,才能被分离出来。
最后,还要反复确认噬菌体和被杀死细菌的关系,才能分离得到专杀这种细菌的噬菌体。
噬菌体形成的噬菌斑
实际上,现实的实验操作比简略的文字描写复杂太多,也枯燥太多。加上还会有各种特殊的情况:样品做完这份还有下一份、这种细菌不能被噬菌体杀死还要尝试下一种细菌、好不容易长出来抑菌圈却发现是实验污染、终于分离出来噬菌体却是和之前一样的噬菌体……
凡此种种、桩桩件件,痛苦又磨人。好在科学家们坚持了下来,分离出的所有噬菌体,一个个走到了我们的眼前。
重复再重复,得到了人体肠道噬菌体资源库(GPIC)值得高兴的是,科学家们最终成功获得了209种能感染肠道细菌的噬菌体——这其中绝大部分噬菌体之前都没有被发现过。这209种噬菌体组成了人体肠道噬菌体资源库GPIC。GPIC中的噬菌体能针对性杀死42种人类肠道细菌,包括15种拟杆菌、19种厚壁菌、4种放线菌和4种变形菌。

GPIC中噬菌体可侵染细菌种类
之前的科学家对肠道的宏基因组做了测序,得到了很多基因组信息,但是不清楚里面哪些基因信息是属于噬菌体,所以无法做数据挖掘和统计。现在,有了GPIC的209种噬菌体基因组信息,终于可以更深入挖掘肠道宏基因组这个宝藏了。
这就好比,之前给科学家拉来了一车又一车杂七杂八的矿石,虽然知道其中有很多宝藏,但是不知道什么样子的矿石才值钱。现在有了一份矿石名录和价格指南,科学家马上就能去统计这一车包含了多少种宝藏、不同宝藏的数量、宝藏的总价值等等……
经过科研团队统计,发现GPIC的中的2株噬菌体PD491P1和AS73P1,在人群中的流行率最高可达43%,远超之前的流行率冠军crAss-like噬菌体。PD491P1和AS73P1这两种噬菌体在全球接近一半人的肚子里都存在,但如果没有肠道噬菌体分离工作,你永远都不知道你肚子里还有这么两种噬菌体。最终,PD491P1和AS73P1及其类似噬菌体被归类为一个新的噬菌体科,暂命名为Paboviridae,暂居人群中流行程度的榜首。
GPIC,未来可期实际上,除了做描述性的工作之外,人体肠道噬菌体资源库GPIC更能为接下来的成果转化提供条件。
在对GPIC噬菌体的基因组做分析时,科研团队发现一些噬菌体的基因组很小(长度在10-20kbp),并且互相之间很相似,这些噬菌体都被归类为Salasmaviridae病毒科。
更有趣的是,它们的宿主细菌分布在几十个种属中,但却出奇一致的都是革兰氏阳性菌(指能够用革兰氏染色染成深蓝或紫色的细菌),包括在人体肠道中广泛存在的双歧杆菌和梭菌。也就是说,科学家发现了一类噬菌体,能专门针对人体肠道中的革兰氏阳性菌,在对付细菌方面多了几件新式的噬菌体武器。

人体肠道高流行率的噬菌体新科Paboviridae的发现与表征(图片来自论文)
长期来看,噬菌体“武器”能丰富现有的肠道感染治疗手段——目前治疗肠道感染通常是使用抗生素,一粒药剂下肚,把肠道的微生物全杀了。病虽然治了,可很多普通细菌甚至益生菌也一起陪葬了,健康的肠道菌群还得慢慢恢复。
这就相当于面对劫持人质的歹徒,该用狙击枪你却搬来了榴弹炮,连歹徒带人质全给轰了。但通常情况下,一种噬菌体能做到只杀一种细菌而不伤害其它细菌,因此GPIC中丰富的噬菌体种类可以用来分别杀灭不用的致病菌。
科研团队从GPIC中选择了8种专门针对脆弱拟杆菌的噬菌体混合到一起,加入到粪便样本的肠道菌群体外培养物中。混合噬菌体添加24h后,脆弱拟杆菌的丰度均显著降低,同时伴随着菌群组成的剧烈变化。
体外实验的成功说明,科学家对“专精狙杀肠道中某一种细菌”这一工作,至少迈出了可行的第一步。希望在不久的将来,这一研究成果能得到应用,在噬菌体的干预下,让肠道菌群真正听我们指挥,让人体的“外挂器官”真正能够开“外挂”。
参考文献
1.《Large-scalephagecultivationforcommensalhumangutbacteria》
2.Ser,R.,Fuchs,S.,Milo,R.(2016).AreWeReallyVastlyOutnumbered?,164(3),337–340.
3.Lozupone,,Stombaugh,,Gordon,,Jansson,,Knight,R.(2012).Diversity,,489(7415),220–230.
4.Luong,T.,Salabarria,,Roach,(2020).PhageTherapyintheResistanceEra:WhereDoWeStandandWhereAreWeGoing?.Clinicaltherapeutics,42(9),1659–1680.
5.
6.